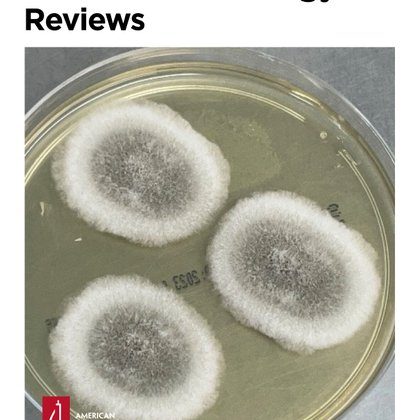
Tweet card summary image

Jürgen Prattes
@jprattes
Followers
321
Following
2K
Media
13
Statuses
457
M.D., FECMM | ID consultant | deep interest in clinical research focused on fungal infections | President of the Austrian Society of Medical Mycology (ÖGMM)
Graz, Austria
Joined October 2009
First retreat of our translational mycology working group 🍄👨🏼💻👩💻 Shaping future research topics and study designs in medical mycology 🦾 @martinhoenigl @SarahSedik @Stella_A_I
0
3
13
Join our Global ECMM Candida IV Study 🍄 @eurconfmedmycol
@EcmmCandidaIV
@martinhoenigl
@Stella_A_I
#ESCMIDGlobal2025
3
6
16
Fully packed 2nd symposium of the austrian society of medical mycology (ÖGMM) - thanks to all speakers and participants for the interactive sessions
0
5
14
Posaconazole for Prevention of COVID‐19‐Associated Pulmonary Aspergillosis in Mechanically Ventilated Patients: A European Multicentre Case–Control Study @jprattes @danieleroberto4 @GangneuxJp @ProfMBassetti @FReizine @eller_philipp @RobertK05753862
https://t.co/V3clIUSOKg
onlinelibrary.wiley.com
Background This study investigated the impact of posaconazole (POSA) prophylaxis in COVID-19 patients with acute respiratory failure receiving systemic corticosteroids on the risk for the developme...
1
11
12
👉Participate in ECMM Candida IV 🌎wide study on candidemia caused by non-albicans Candida spp. Requirement: clinical data & isolate (not req for C.auris) Reward: Reimbursement & Authorship Observation period: 04/2024 - 09/2025 Interested? 📧 stella.wolfgruber@medunigraz.at
3
8
17
Proud of the results of a fantastic collaboration with @MSG_ERC We invite all our followers and members to review and comment on the revised clinical outcome criteria on aspergillosis and other molds.
Along w/ @eurconfmedmycol, we are seeking public comments on revised clinical outcome criteria for aspergillosis & other mold infections until 11/30 Draft: https://t.co/PMJX50V01Z Supplement: https://t.co/FcisXGX1uS PW: ECMMMSGERCNov2024asp 📧comments to headquarters@msgerc.org
2
7
8
Along w/ @eurconfmedmycol, we are seeking public comments on revised clinical outcome criteria for aspergillosis & other mold infections until 11/30 Draft: https://t.co/PMJX50V01Z Supplement: https://t.co/FcisXGX1uS PW: ECMMMSGERCNov2024asp 📧comments to headquarters@msgerc.org
0
18
22
My interview for austrian national television on attributable mortality of candidemia and the ECMMCandida III study. Great study @SalmantonGarcia @KoehlerPh @CornelyOliver and others! @eurconfmedmycol @MedUniGraz
on.orf.at
Toter Mann in Hotelzimmer | Brand auf Linzer Schießstand | Wiener Raser in 30er-Zone gefasst | Erste Sprengung auf dem Plöckenpass | Junge Menschen besonders von Teuerung betroffen | Schuldenberater:...
1
9
36
Comparative Analysis of the Clarus Aspergillus Galactomannan Enzyme Immunoassay Prototype for the Diagnosis of Invasive Pulmonary Aspergillosis in Bronchoalveolar Lavage Fluid @SarahSedik @jprattes @MatthiasEgger11 @SpringerMicBio
https://t.co/G4gQudEyJ5
link.springer.com
Mycopathologia - Galactomannan (GM) testing using Platelia Aspergillus enzyme immunoassay (Platelia AGM) from bronchoalveolar lavage fluid (BALF) aids in early diagnosis of invasive pulmonary...
0
7
28
Influenza-associated and COVID-19-associated pulmonary aspergillosis in critically ill patients @s_feys @carvalho_ago @ClancyNeil @GangneuxJp @lagrou_katrien @bjarijn
https://t.co/HfpPBU52PU
0
15
31
Posa prophylaxis to prevent CAPA? Yes for centers with high-baseline CAPA rates and targeted in high-risk patients (e.g. EORTC risk factors present), no for others. https://t.co/lzc6EspRre
@martinhoenigl @danieleroberto4 @ProfMBassetti @GangneuxJp
0
4
13
🍄Antifungal prophylaxis of #COVID19 associated pulmonary aspergillosis in pts on MV. Significant variation in CAPA incidence among centers not using prophylaxis (lower or significantly higher) vs center providing prophylaxis despite similar diagnostics. 🖇️ https://t.co/tFk1N807rN
0
9
12
Most patients with sepsis don't need anti-anaerobic antibiotics. But most get them anyway. Why not, what's the harm? I worry the harm is considerable. Our new study in @JAMAInternalMed: using a 15-month pip-tazo shortage to answer this question. 1/n https://t.co/1nOhsUaio0
32
249
683
Our #ECCMID2024 get-together will take place at 🚩Alice Secret Garden https://t.co/deuIYh6fDH 📋RSVP still online https://t.co/RRsElEATPj See you 🍄
1
12
16
🔥📰from CMR: Novel antifungals and Tx approaches to tackle resistance and improve outcomes of invasive fungal disease @ASMicrobiology @CDCgov @GRThompsonMD @carvalho_ago @MatthiasEgger11 @s_feys @GangneuxJp @RobertK05753862 @lagrou_katrien @jprattes
journals.asm.org
SUMMARYFungal infections are on the rise, driven by a growing population at risk and climate change. Currently available antifungals include only five classes, and their utility and efficacy in...
1
28
53
Are you under 40 years of age and want to be part of an international program in your early career in mycology? ➡️Join @YoungECMM and enjoy its benefits 🔗Apllication form https://t.co/F7icd15A5L 🍄Further info on https://t.co/eHut9TOOPf Looking forward to connect and thrive 💫
ecmm.info
Welcome to the Young ECMM programme Become the face of the next generation in medical mycology, become a Young ECMM fellow. Be part of the international programme in your early career in mycology to...
0
16
30
#ÖGMM-Symposium zu invasive Mykosen am 09.04.24🍄im Hotel Brandlhof. Ab 13:30h (fast) alles Wissenswerte über Pilzinfektionen --> Keine Registrierung, keine Gebühren. Einfach teilnehmen 🥳🧐 @martinhoenigl @RobertK05753862 und viele weitere Expert:innen! https://t.co/FzQmQ4dq63
0
2
6
YECMM is planning a 🍄 get-together during #ECCMID2024 ! Are you a young clinician/scientist interested in mycology ? Join us on Sunday 28/04. 👉 RSVP : https://t.co/RRsElEATPj [Form to register will be sent shortly to those who RSVP and are interested to join YECMM]
0
14
32
CAPA in Patients Admitted to the Intensive Care Unit: Impact of Antifungal Prophylaxis Posaconazole ⬇️CAPA incidence rate at our center. Future trials will focus on a more nuanced, risk-factors based prophylactic approach. @martinhoenigl @reisinger_alex
https://t.co/CkAqVFFlfC
0
7
20
Risk of COVID-19-associated pulmonary aspergillosis: time for a nuanced approach to antifungal prophylaxis? https://t.co/9v9DFF4Ek4 Learning about the individual risk for #CAPA development will allow for a more individualized #COVID19 management @martinhoenigl @LancetRespirMed
1
14
30